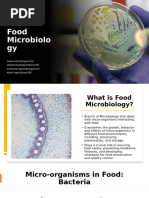

FAT TOM is a mnemonic device that is used in the food service industry to describe the six favorable conditions
required for the growth of foodborne pathogens. It is an acronym for food, acidity, time, temperature, oxygen and moisture.
F A T T O
M
Food Acidity Time Temperature Oxygen Moisture
There are sufficient nutrients available that promote the growth of microorganisms. Protein-rich foods, such as meat, milk, eggs and fish are most susceptible. Foodborne pathogens require a slightly acidic pH level of 4.6-7.5, while they thrive in conditions with a pH of 6.6-7.5. FDA regulations for acid/acidified foods require that the food be brought to pH 4.5 or below. Food should be removed from "the danger zone" (see below) within two hours, either by cooling or heating. While most guidelines state two hours, a few indicate four hours is still safe. Foodborne pathogens grow best in temperatures between 41 F (5 C) to135 F (57 C), a range referred to as the temperature danger zone (TDZ). They thrive in temperatures that are between 70 F (21 C) to 120 F (49 C). Almost all foodborne pathogens are aerobic, that is requiring oxygen to grow. Some pathogens, such as clostridium botulinum, the source ofbotulism, are anaerobic and do not require oxygen to grow. Water is essential for the growth foodborne pathogens, water activity (wa) is a measure of the water available for use and is measured on a scale of 0 to 1.0. Foodborne pathogens grow best in foods that have a wa between 1.0 and 0.86. FDA regulations for canned foods require wa of 0.85 or below Food Intoxication more prevalent symptoms include nausea and vomiting and the onset time, or time between consumption of food and first sign of symptoms, is shorter. This makes sense because essentially you are experiencing a chemical poisoning and your body tends to react or respond quicker. Depending on the amount of toxin present and your bodys reaction, you can experience symptoms in as little as 2 hours after consumption. The most common microorganisms responsible for food intoxications includeStaphylococcus aureus, Escherichia coli O157, Clostridium perfigens, and Clostridium botulinum. Food Infection more prevalent symptoms include diarrhea, stomach cramps, fever and chills (fever and chills are rarer in an intoxication). With an infection, remember it is the actual cells, or virus that is causing your symptoms and it takes time for the cells to reproduce and start attacking your intestine or other parts or your body as may be the case for viruses.
A hypha (plural hyphae) is a long, branching filamentous structure of [1] a fungus, and also of unrelated Actinobacteria. In most fungi, hyphae are the main mode of vegetative growth, and are collectively called a mycelium; yeasts are unicellular fungi that do not grow as hyphae.
A flagellum plural: flagella) is a tail-like projection that protrudes from the cell body of [1][2][3] certain prokaryotic and eukaryotic cells, and functions in locomotion. There are some notable differences between prokaryotic and eukaryotic flagella, such as protein composition, structure, and mechanism of propulsion. An example of a flagellated bacterium is the ulcer-causing Helicobacter pylori, which uses multiple flagella to propel [4] itself through the mucus lining to reach the stomach epithelium. An example of a eukaryotic flagellated cell is the sperm cell, which uses its flagellum to propel itself [5] through the female reproductive tract. Eukaryotic flagella are structurally identical to eukaryotic cilia, although distinctions are sometimes made according to function and/or length